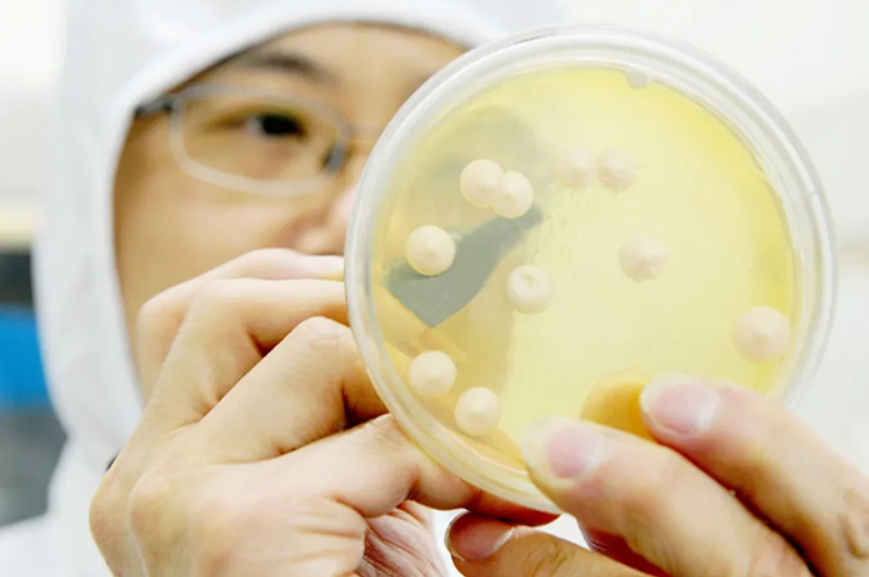

近日,安琪酵母披露2022年财报。根据财报显示,报告期内安琪酵母营收净利润双双增长,应收账款高企。截至本报告期末,公司营业总收入128.43亿元,同比上升20.31%,归母净利润13.21亿元,同比上升0.97%;基本每股收益为1.5684 元,同比下降 1.23%;加权平均净资产收益率 16.47%,同比下降 4.07 个百分点。

安琪酵母是A股酵母行业唯一的上市公司,是专业从事酵母、酵母衍生物及相关生物制品经营的国家重点高新技术企业,目前为亚洲第一、全球第二大酵母公司。
01
业绩回暖可圈可点
2022年对于安琪酵母而言是关键的一年。从整体环境来看,俄乌战争、疫情封控等因素影响了安琪酵母的整体动销。
从成本端来看,在酵母生产中,糖蜜是重要的原材料。据安琪酵母互动易透露,理论上,一吨酵母需要消耗 4.5-5.5 吨糖蜜。年报披露:"公司主要原材料为糖蜜,目前国内糖蜜供应日趋紧张,导致糖蜜价格上涨幅度较大,同时其他辅料采购价格也呈现上涨趋势,直接导致公司生产成本大幅增加。
在这样的背景下,安琪酵母能够实现营收和净利润双增,表现也算是可圈可点。
分业务来看,2022年,公司酵母及深加工产品收入90.20亿元,同比增长12.98%,占营业收入的70.23%;制糖产品收入17.66亿元,同比增长68.09%,占营业收入的13.75%;包装类产品收入4.78亿元,同比增长13.92%,占营业收入的3.72%。
从销售区域来看,国内市场实现主营业务收入88.68亿元,同比增长13.92%;国际市场实现主营业务收入折算人民币39.23亿元,同比增长39.02%。

国际市场增长速度高于国内市场,得益于公司长期坚持的国际化战略布局,坚定推进海外子公司建设和营销人员本土化,推进渠道下沉和二次开发,抢抓海外市场恢复快、制造成本上升的机遇,大力开发新的经销商和大用户,国际业务收入取得较快增长。
与此同时,安琪酵母还不断加强对电商新模式、新渠道的研究,努力提升线上渠道覆盖率和市场占有率。
02
产能扩建剑指140亿
2023年,安琪酵母确定了实现销售收入143.9亿元、归母净利润同比增长10.21%的经营目标。复盘安琪酵母近两年的发展,不难发现其一直在寻求产能的提升、技术的改良。尤其是近一年来,动作不断。
去年7月份,安琪酵母表示公司拟设立安琪酵母(铁岭)有限公司并实施年产5万吨生物发酵饲料绿色制造项目,项目总投资1.19亿元。公司拟与北京微构工场生物技术有限公司(简称“微构工场”)合资设立湖北微琪生物科技有限公司(简称“微琪生物”)共同推进万吨级聚羟基脂肪酸酯产业化项目。合资公司注册资本为1亿元,其中微构工场现金出资6000万元,占股比例60%;公司现金出资4000万元,占股比例40%。
接着,9月份表示,为匹配酶制剂生产线现有的工艺设备技术,考虑到未来酶制剂产品市场需求可能出现快速增加和日后其余生物制品的发展,公司控股子公司安琪酶制剂(宜昌)有限公司拟对募投项目年产5000吨新型酶制剂绿色制造项目进行变更,由原来规划的新建年产3500吨酶制剂和搬迁年产1500吨酶制剂制造项目变更为全部新建实施年产5000吨酶制剂绿色制造项目,投资预算由3.3988亿元变更为4.017亿元,投资增加6182万元。

同时,安琪酵母为促进公司控股子公司湖北宏裕新型包材股份有限公司(简称“宏裕包材”)塑料包装业务板块做大做强,公司于2022年6月启动分拆上市。2023年3月9日,宏裕包材已向北交所提交了问询函回复,等待后续审批。
今年以来,为满足公司海内外业务发展需求,公司筹划境外发行全球存托凭证(简称:GDR),并在瑞士证券交易所挂牌上市事宜。报告期内已取得了宜昌市国资委同意发行GDR的批复,同时将GDR申报材料报送至中国证券监督管理委员会等待批复。公司将借助本次GDR发行,募集资金拓展海内外业务,进一步提升公司全球行业地位。
03
关于酵母提取物
近年来,酵母抽提物的使用被证实符合国家卫生健康委员会“三减三健”专项行动的要求,它是食品企业开发减盐、减糖、减脂产品的理想食品配料,将在推动实现《“健康中国2030”规划纲要》《国民营养计划(2017-2030年)》提出的“三减”目标过程中发挥重要作用。
酵母抽提物为何具有神奇的“减盐增鲜”效应?
鲜味是因为部分食物中含有丰富的蛋白质、氨基酸、多肽、核苷酸等美味物质。而酵母抽提物恰好富含这些营养成分,因此具有与生俱来的增鲜效应。
酵母抽提物的“减盐”,是因为人体舌尖味蕾对食盐(钠离子)的感受非常敏感,如果钠含量降低,人们对鲜味的感受就差很多。酵母抽提物的营养成分可有效增加味蕾对鲜味的感受量,在低钠盐的情况下,使人体感知到食物的鲜美,从而达到“减盐不减味”的神奇效应。
正是因为酵母提取物的这一功能,安琪酵母在投资者的互动平台上表示YE广泛应用于休闲食品、肉制品、方便面、酱油等食品调味领域,随着工艺、技术的发展,也有部分类型的YE逐步应用于生物发酵、医药发酵、化妆品等领域。
而且,在安琪酵母的官网中也介绍到经过十几年的推广,安琪酵母抽提物(YE)已在调味品、食品中广泛应用,出口欧美、日韩等140多个发达国家和地区。企业先后在湖北宜昌、新疆伊犁、广西崇左、柳州,埃及新建了五条酵母抽提物生产线,其总产能达7.3万吨。
从发展的角度来看,疫情管控政策进一步优化的2023年对于安琪酵母而言是举足轻重的一年。一方面,扩建产能的进程持续推进,但也要注意到存货问题。另一方面,对于安琪酵母而言,保质增效、开源节流、优化营销策略等也十分重要。